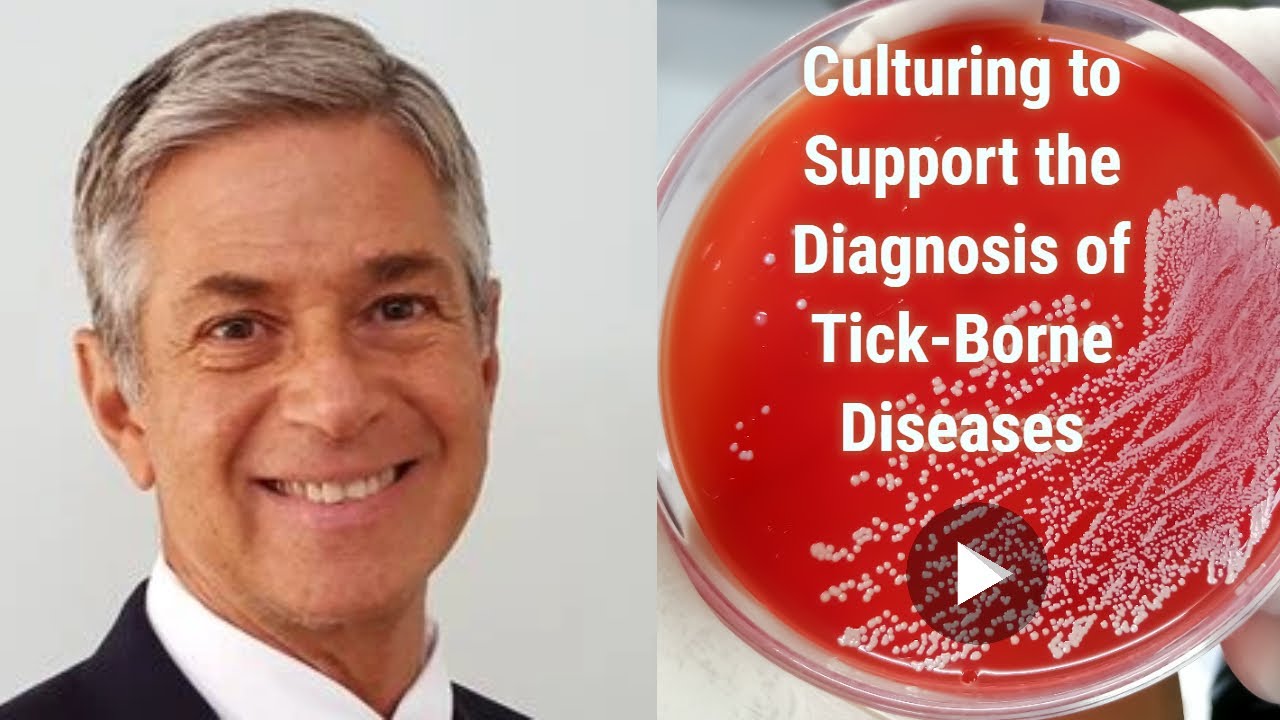
Webinar: IGeneX Culture Testing to Support the Diagnosis of Tick-Borne Diseases

Webinar: IGeneX Culture Testing to Support the Diagnosis of Tick-Borne Diseases скачать в хорошем качестве
Повторяем попытку...
Скачать видео с ютуб по ссылке или смотреть без блокировок на сайте: Webinar: IGeneX Culture Testing to Support the Diagnosis of Tick-Borne Diseases в качестве 4k
У нас вы можете посмотреть бесплатно Webinar: IGeneX Culture Testing to Support the Diagnosis of Tick-Borne Diseases или скачать в максимальном доступном качестве, видео которое было загружено на ютуб. Для загрузки выберите вариант из формы ниже:
-
Информация по загрузке:
Скачать mp3 с ютуба отдельным файлом. Бесплатный рингтон Webinar: IGeneX Culture Testing to Support the Diagnosis of Tick-Borne Diseases в формате MP3:
Если кнопки скачивания не
загрузились
НАЖМИТЕ ЗДЕСЬ или обновите страницу
Если возникают проблемы со скачиванием видео, пожалуйста напишите в поддержку по адресу внизу
страницы.
Спасибо за использование сервиса ClipSaver.ru
Webinar: IGeneX Culture Testing to Support the Diagnosis of Tick-Borne Diseases
It has been five months since IGeneX launched its revolutionary cePCR (Culture Enhanced PCR) test for all the major tick-borne diseases. Join Dr. Joseph Burrascano and Dr. Jyotsna Shah for an in-depth webinar as we highlight our learnings thus far. In this webinar, you will learn: • The advantages of culture testing for tick-borne diseases • Why including culturing is essential for a complete picture of your patient • Why immune deficient patients may have a negative serology but a positive culture • Why patients with inactive disease (or those on medication) may have a negative culture but a positive serology • View actual patient data that will help you in your practice!



















